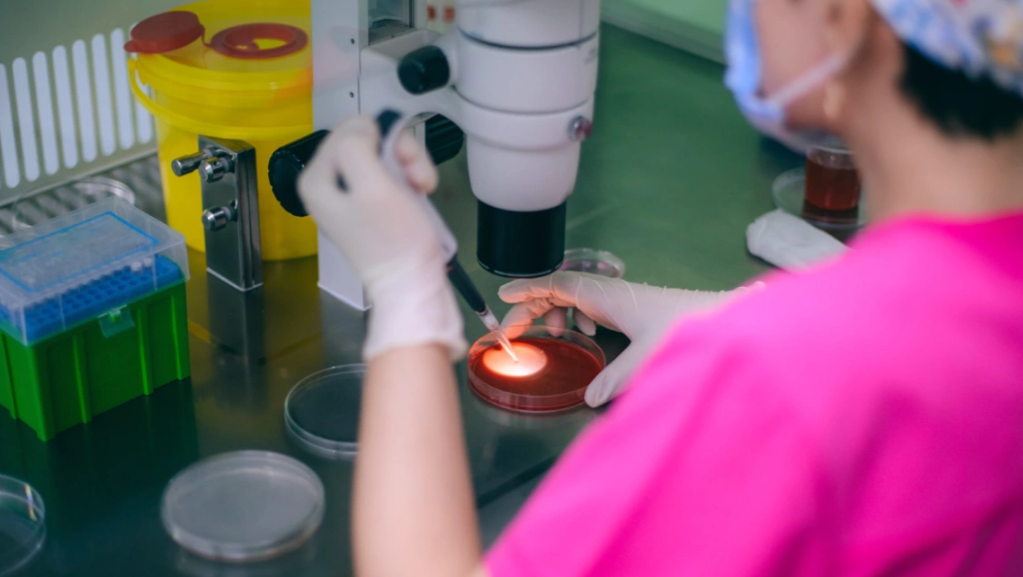
Dhuruesi i spermës i kaloi gjenin e kancerit 197 fëmijëve në vendet evropiane, përfshirë Shqipërinë

Një dhurues sperme, i cili pa dijeninë e tij mbante një mutacion gjenetik që rrit në mënyrë dramatike rrezikun e kancerit, ka qenë baba i të paktën 197 fëmijëve në të gjithë Europën, ka zbuluar një hetim i madh. Disa fëmijë kanë vdekur tashmë dhe vetëm një pakicë e atyre që trashëgojnë mutacionin do t’i shpëtojnë kancerit gjatë jetës së tyre.
Sperma nuk është shitur në klinikat britanike, por BBC-ja ka konfirmuar se një numër “shumë i vogël” familjesh britanike, të cilat janë njoftuar, kanë përdorur spermën e dhuruesit gjatë trajtimit të fertilitetit në Danimarkë. Banka Europiane e Spermës në Danimarkë, e cila e shiti spermën, tha se familjet e prekura kishin “ngushëllimet më të thella” të tyre dhe pranoi se sperma ishte përdorur për të krijuar shumë foshnja në disa vende. Hetimi është kryer nga 14 transmetues publikë, përfshirë BBC-në, si pjesë e Rrjetit të Gazetarisë Investigative të Unionit Europian të Transmetimeve.
Sperma vinte nga një burrë anonim, i cili paguhej për dhurimin kur ishte student, duke filluar nga viti 2005. Sperma e tij u përdor nga gra për rreth 17 vjet. Ai është i shëndetshëm dhe i kaloi kontrollet e skriningut për dhuruesit. Megjithatë, ADN-ja e disa prej qelizave të tij u mutua para se ai të lindte. Mutacioni dëmtoi gjenin TP53 – i cili ka rolin kritik në parandalimin e kthimit të qelizave të trupit në kancerogjene.
Shumica e trupit të dhuruesit nuk përmban formën e rrezikshme të TP53, por deri në 20% të spermës së tij po. Megjithatë, çdo fëmijë i krijuar nga kjo spermë do të ketë mutacionin në çdo qelizë të trupit. Kjo njihet si sindroma Li-Fraumeni dhe sjell deri në 90% shans për zhvillimin e kancerit, veçanërisht gjatë fëmijërisë, si dhe kancer të gjirit më vonë gjatë jetës.
“Është një diagnozë tmerrshme,” tha për BBC-në prof. Clare Turnbull, gjenetiste e kancerit në Institutin e Kërkimeve të Kancerit në Londër. “Është një diagnozë jashtëzakonisht sfiduese për një familje, ka një barrë të përjetshme të jetuarit me këtë rrezik, është qartazi shkatërruese.”
Çdo vit nevojiten skanime MRI të trupit dhe trurit, si dhe ekografi abdominale, për të tentuar të zbulojnë tumore. Gratë shpesh zgjedhin të heqin gjoksin për të ulur rrezikun e kancerit. Banka Europiane e Spermës tha se “vetë dhuruesi dhe anëtarët e familjes së tij nuk janë të sëmurë” dhe se një mutacion i tillë “nuk zbulohet preventivisht nga skriningu gjenetik”. Ata thanë se “e bllokuan menjëherë” dhuruesin sapo u zbulua problemi me spermën e tij.
Fëmijë kanë vdekur
Mjekët që po trajtonin fëmijë me kancer të lidhur me donacionin e spermës ngritën shqetësime në Shoqatën Europiane të Gjenetikës Humane këtë vit. Ata raportuan se kishin gjetur 23 fëmijë me variantin gjenetik nga 67 fëmijë të njohur deri atëherë. Dhjetë prej tyre ishin diagnostikuar tashmë me kancer.
Përmes kërkesave për informacion publik dhe intervistave me mjekë dhe pacientë, ne arrijmë të zbulojmë se një numër dukshëm më i madh fëmijësh kanë lindur nga ky dhurues. Shifra është të paktën 197 fëmijë, por kjo mund të mos jetë përfundimtare pasi nuk ka të dhëna nga të gjitha vendet.
Nuk dihet gjithashtu sa prej këtyre fëmijëve trashëguan variantin e rrezikshëm. Dr. Edwige Kasper, gjenetiste kanceri në Spitalin Universitar të Rouen në Francë, e cila paraqiti të dhënat fillestare, i tha hetimit: “Ne kemi shumë fëmijë që tashmë kanë zhvilluar kancer.
“Kemi disa fëmijë që kanë zhvilluar tashmë dy lloje të ndryshme kanceri dhe disa prej tyre kanë vdekur në moshë shumë të hershme.” Céline, jo emri i saj i vërtetë, është një nënë e vetme në Francë, fëmija i së cilës u konceptua me spermën e dhuruesit 14 vjet më parë dhe ka mutacionin. Ajo mori një telefonatë nga klinika e fertilitetit në Belgjikë duke i kërkuar ta çonte vajzën për skrining. Ajo thotë se nuk ka “absolutisht asnjë ndjenjë negative” ndaj dhuruesit, por e quan të papranueshme që i dha spermë që “nuk ishte e pastër, nuk ishte e sigurt, mbante një rrezik”.
Dhe ajo e di se kanceri do të qëndrojë si kërcënim mbi ta për pjesën tjetër të jetës. “Nuk e dimë kur, nuk e dimë cilin lloj, dhe nuk e dimë sa herë,” thotë ajo. “E kuptoj që ka shumë gjasa të ndodhë, dhe kur të ndodhë, do të luftojmë dhe nëse ka disa herë, do të luftojmë disa herë.”
Ku u dërgua sperma e dhuruesit?
Sperma e dhuruesit u përdor nga 67 klinika fertiliteti në 14 vende. Sperma nuk u shit në klinikat e MB-së. Megjithatë, si rezultat i këtij hetimi, autoritetet në Danimarkë njoftuan të hënën Autoritetin Britanik të Fertilizimit dhe Embriologjisë (HFEA) se gra britanike kishin udhëtuar drejt vendit për të marrë trajtim fertiliteti duke përdorur spermën e dhuruesit. Ato gra janë njoftuar.
Peter Thompson, shefi ekzekutiv i HFEA-së, tha se një “numër shumë i vogël” grash u prekën dhe “ato janë informuar për dhuruesin nga klinika daneze ku janë trajtuar”. Nuk dihet nëse ndonjë grua britanike ka marrë trajtim në vende të tjera ku është shpërndarë sperma e dhuruesit. Prindërve të shqetësuar u këshillohet të kontaktojnë klinikën që kanë përdorur dhe autoritetin e fertilitetit në atë vend.BBC ka vendosur të mos publikojë numrin identifikues të dhuruesit, sepse ai dhuroi me mirëbesim dhe rastet e njohura në MB janë kontaktuar.
Nuk ka një ligj global mbi sa herë mund të përdoret sperma e një dhuruesi. Megjithatë, vendet individuale vendosin kufijtë e tyre. Banka Europiane e Spermës pranoi se këta kufij “fatkeqësisht” janë shkelur në disa vende dhe se ajo është “në dialog me autoritetet në Danimarkë dhe Belgjikë”. Në Belgjikë, një dhurues i vetëm sperme duhet të përdoret vetëm nga gjashtë familje. Në vend të kësaj, 38 gra të ndryshme sollën në jetë 53 fëmijë nga ky dhurues.Kufiri në MB është 10 familje për dhurues.
‘Nuk mund të bësh skrining për gjithçka’
Prof. Allan Pacey, i cili drejtonte Sheffield Sperm Bank dhe tani është nënkryetari i Fakultetit të Mjekësisë Biologjike dhe Shëndetit në Universitetin e Manchester-it, tha se vendet janë bërë të varura nga bankat e mëdha ndërkombëtare të spermës dhe se gjysma e spermës në MB tani importohet.
Ai i tha BBC-së: “Ne duhet të importojmë nga bankat e mëdha ndërkombëtare të spermës që gjithashtu e shesin atë në vende të tjera, sepse kështu fitojnë para, dhe këtu qëndron problemi, sepse nuk ka ligj ndërkombëtar për sa shpesh mund të përdoret sperma.”
Ai tha se rasti ishte “i tmerrshëm” për të gjithë të përfshirët, por është e pamundur të bëhet sperma plotësisht e sigurt. “Nuk mund të bësh skrining për gjithçka; ne pranojmë vetëm 1%–2% të të gjithë burrave që aplikojnë për të qenë dhurues sperme me rregullat aktuale të skriningut, prandaj nëse e bëjmë edhe më të rreptë, nuk do të kishim fare dhurues – aty është ekuilibri.” Ky rast, së bashku me atë të një burri që u urdhërua të ndalonte pasi kishte bërë 550 fëmijë përmes dhurimit të spermës, ka hapur sërish pyetje nëse duhet të ketë kufij më të rreptë.
Shoqata Europiane e Riprodhimit dhe Embriologjisë Humane ka propozuar së fundmi një limit prej 50 familjesh për dhurues. Megjithatë, tha se kjo nuk do të ulte rrezikun e trashëgimit të sëmundjeve të rralla gjenetike.Në vend të kësaj, do të ishte më e dobishme për mirëqenien e fëmijëve që zbulojnë se janë një nga qindra gjysmë-vëllezër e motra.
“Duhet bërë më shumë për të ulur numrin global të familjeve që lindin nga të njëjtët dhurues,” tha Sarah Norcross, drejtoresha e Progress Educational Trust, një organizatë e pavarur për njerëzit e prekur nga infertiliteti dhe kushtet gjenetike Nuk e kuptojmë plotësisht se cilat do të jenë pasojat sociale dhe psikologjike të të pasurit qindra gjysmë-vëllezër. Mund të jetë potencialisht traumatike,” i tha ajo BBC News.
Banka Europiane e Spermës tha: “Është e rëndësishme, sidomos në dritën e këtij rasti, të kujtojmë se mijëra gra dhe çifte nuk do të kishin mundësi të kishin një fëmijë pa ndihmën e spermës së dhuruesit. Në përgjithësi është më e sigurt të kesh një fëmijë me ndihmën e spermës së dhuruesit, nëse dhuruesit kontrollohen sipas udhëzimeve mjekësore.”/BBC
Tag: fëmijë
-

BBC: Në Shqipëri dhe 13 shtete të tjera u përdor sperma nga një dhurues me…
-

Shokuese nga Australia/ Eshtrat e një fëmije 18 muajsh shqiptar gjenden në një varr të cektë në oborr
Trupi i një fëmije të vogël është gjetur i varrosur në një varr të cekët në oborrin e një shtëpie nga policia që po hetonte një zhdukje.
Zbulimi i tmerrshëm i djalit 18-muajsh u bë në një banesë në Brookfield, në veriperëndimin e jashtëm të Melburnit.
Policisë iu deshën rreth gjashtë orë për të gjetur atë që kërkonin, pasi filluan gërmimet të hënën.
Fëmija ishte varrosur në një varr vetëm 50 cm të thellë dhe është e mundur që eshtrat e tij të kenë qenë aty për më shumë se një dekadë.
Sipas 7News, ai kishte jetuar në atë shtëpi me prindërit dhe dy vëllezërit e motrat e tij në vitin 2014, para se të ktheheshin jashtë vendit, ndoshta në Shqipëri.
Ai nuk ishte raportuar i zhdukur në atë kohë.
Pronari aktual i shtëpisë u takua me policinë, e cila i shpjegoi se dyshohej që një trup ishte varrosur vetëm disa metra larg derës së pasme.
‘Diçka e tillë nuk duhet të ndodhë, por ka ndodhur 14 vjet më parë. Diçka shumë e keqe. Shumë e tmerrshme’, tha ai për 7News.
Policia e Viktorias theksoi se banorët aktualë nuk kanë asnjë njohuri apo lidhje me hetimin ose me personat që kanë jetuar më parë në atë pronë.
Mbetjet ende nuk janë identifikuar zyrtarisht.
‘Koroneri është njoftuar dhe një autopsi do të kryhet në kohën e duhur’, njoftoi Policia e Viktorias.
‘Njësia për Personat e Zhdukur do të marrë drejtimin e hetimit, i cili mbetet në vazhdim.’
Duket se policia është sinjalizuar nga një i afërm i fëmijës, i cili nuk ka mundur ta mbajë më sekretin.
Nuk është ende e qartë nëse autoritetet australiane janë vënë në kontakt me autoritetet shqiptare, por Australia ka një traktat ekstradimi me vendin ballkanik.
-

Platforma kundër shpopullimit/ Berisha: Pagesa nga 1 mijë deri në 5 mijë euro për fëmijë
Kreu i PD-së, Sali Berisha, prezantoi sot platformën kundër shpopullimit, duke propozuar pagesa nga 1 deri në 5 mijë euro për çdo fëmijë të lindur, sipas renditjes së tyre në familje.
Ai tha se për çdo vit me rreth 30 mijë lindje, paketa do të kushtojë rreth 60 milionë euro. Berisha njoftoi edhe bonuse mujore prej 50 euro për fëmijët deri në 6 vjeç dhe 60 euro për ata nga 6 deri 18 vjeç, me një kosto vjetore 15 milionë euro.
Paketa përfshin gjithashtu çerdhe e kopshte falas për fëmijën e tretë e më tej, si dhe rimbursim ilaçesh prej 120 euro në vit për ta. Ai theksoi se masat synojnë të frenojnë krizën demografike në vend.
Deklarata
Për t’i dhënë një përgjigje kësaj katastrofe ekzistenciale demografike të shqiptarëve në Shqipëri, PD mendon se duhet të fillohet këtë vit me buxhetin për fëmijët që lindin dhe për fëmijët.Fëmija e parë të ketë një trajtim mujor 1 mijë euro në vit.Fëmija e dytë 2 mijë euro.Fëmija e tretë 3 mijë euro bonus.Fëmija e katërt dhe më shumë, 5 mijë euro bonus.Të gjitha këto të përllogaritura për 30 mijë lindje në vit, shkojnë 60 milionë euro sepse ne kemi përllogaritur edhe kostot e kësaj ndërhyrje.Bonusi mujor për fëmijët e lindur, ato ishin bonus i përnjëhershëm, bonusi mujor për fëmijët e lindur, me këtë buxhet, pra për vitin 2026, të jetë 50 euro për çdo fëmijë gjer në moshën 6 vjeç.60 euro për çdo fëmijë, në moshën 6 deri 18-vjeçare.Vlera në vit për 30 mijë lindje i bie të jetë 15 milionë euro.Zero pagesë për fëmijën e tretë apo më shumë për çerdhe dhe kopshte.Të gjitha i paguan shteti.Me këtë mbështeten të paktën 15 mijë fëmijë në vit dhe shuma e nevojshme nga buxheti për këtë masë është 5 milionë euro.Rimbursim të ilaçeve për fëmijën e tretë apo më shumë në masën 120 euro në vit.Të paktën 8 mijë fëmijë përfitojnë nga kjo dhe shumë është 1 milion euro në vit rimbursim i plotë. -

Berisha prezanton platformën e PD kundër shpopullimit: 50 euro në muaj dhe 1 mijë euro bonus lindjeje për fëmijën e parë
Kryetari i Partisë Demokratike, Sali Berisha po mban një konferencë nga selia blu, ku u shpreh se një nga shqetësimet kryesore me të cilat përballet sot populli shqiptar është shpopullimi.
Ai ka prezantuar një platformë të përpiluar nga PD në lidhjen me luftimin e shpopullimit dhe nxitjen e lindshmërisë, masa që sipas Berishës duhet të merren që me buxhetin për vitin e ardhshëm.
“Shpopullimi masiv i Shqipërisë përbën goditjen më të rëndë ekzistenciale që kombi shqiptar ka marrë në tërë historinë e tij të gjatë.Kurrë ndonjëherë, treguesit themelorë të popullsisë të këtij vendi, nuk kanë rënë brenda 10 viteve një shekull.Nuk është regjistruar kurrë një kastastrofë e tillë demografike, siç është regjistruar në 10 vitet e qeverisjes së Eid Ramës 2014-2024.Lindshmëria në Shqipëri sot është e barabartë me lindshmërinë që kishte kur shqiptarët ishin 700 mijë banorë, 100 vite më parë.
Jam ndalur shumë herë në këtë akt të planifikuar që përbën një gjenocid të vërtetë ndaj shqiptarëve në kuptimin e krijimit të kushteve për largimin nga vendi i tyre.Konventa e OKB, neni 3 i saj, shpall këtë rrethanë si një rrethanë të gjenocidit të heshtur, paqësor që mund të ushtrohet ndaj një populli.
Ky gjenocid tejkalon në përmasat e veta çdo lloj katastrofë demografike që shqiptarët kanë përjetuar nga Mesjeta gjer sot, qoftë nga pushtimet, qoftë nga epidemitë e murtajës dhe epidemitë e tjera të rënda.
Sot është emergjencë absolute vendosja e një platforme, e cila të mund të shënojë kthesën e treguesve demografikë të popullit shqiptar, në mënyrë që ky popull të mos shkojë drejt zhdukjes të pashmangshme me këto tregues që ka sot.Nga viti 2018 gjer sot, vdekjet në Shqipëri janë qartësisht më të larta se lindjet.Po të shtojmë këtu edhe largimet masive nga vendi, boshatisja e Shqipërisë është e garantuar.PD mendon se duhet të fillohet këtë vit me buxhetin për fëmijët
Bonusi mujor për fëmijët e lindur të jetë 50 euro për çdo fëmijë deri në moshën 6 vjeç, 60 euro deri në moshën 18-vjeçare.Për t’i dhënë një përgjigje kësaj katastrofe ekzistenciale demografike të shqiptarëve në Shqipëri, PD mendon se duhet të fillohet këtë vit me buxhetin për fëmijët që lindin dhe për fëmijët.Fëmija e parë të ketë një trajtim mujor 1 mijë euro në vit.Fëmija e dytë 2 mijë euro.Fëmija e tretë 3 mijë euro bonus.Fëmija e katërt dhe më shumë, 5 mijë euro bonus.
Të gjitha këto të përllogaritura për 30 mijë lindje në vit, shkojnë 60 milionë euro sepse ne kemi përllogaritur edhe kostot e kësaj ndërhyrje.
Bonusi mujor për fëmijët e lindur, ato ishin bonus i përnjëhershëm, bonusi mujor për fëmijët e lindur, me këtë buxhet, pra për vitin 2026, të jetë 50 euro për çdo fëmijë gjer në moshën 6 vjeç.60 euro për çdo fëmijë, në moshën 6 deri 18-vjeçare.Vlera në vit për 30 mijë lindje i bie të jetë 15 milionë euro.Zero pagesë për fëmijën e tretë apo më shumë për çerdhe dhe kopshte.Të gjitha i paguan shteti.
Me këtë mbështeten të paktën 15 mijë fëmijë në vit dhe shuma e nevojshme nga buxheti për këtë masë është 5 milionë euro.Rimbursim të ilaçeve për fëmijën e tretë apo më shumë në masën 120 euro në vit.Të paktën 8 mijë fëmijë përfitojnë nga kjo dhe shumë është 1 milion euro në vit rimbursim i plotë”, u shpreh Berisha. -

“1 mijë euro bonus për fëmijën e parë…”, Berisha propozon platformë kundër shpopullimit
Kryetari i Partisë Demokratike, Sali Berisha, gjatë konferencës së tij të përditshme për mediat, ngriti alarmin për shpopullimin masiv të vendit, të cilin e cilësoi si “goditjen më të rëndë ekzistenciale” që kombi shqiptar ka marrë në historinë e tij.
Berisha tha se treguesit demografikë të Shqipërisë nuk kanë pësuar kurrë rënie të tillë brenda një periudhe kaq të shkurtër, duke akuzuar qeverinë Rama për “katastrofën më të madhe demografike të regjistruar ndonjëherë në vend”.
Ai e përshkroi situatën si një proces të planifikuar që “përbën gjenocid të heshtur ndaj shqiptarëve”, duke iu referuar konventave ndërkombëtare që trajtojnë çështjet e zhdukjes së popullsive përmes mjeteve jo të dhunshme.
Sipas tij, Shqipëria ndodhet në një moment emergjence absolute dhe kërkon një platformë të qartë që të përmbysë trendin negativ të lindshmërisë dhe emigracionit masiv. Berisha paralajmëroi se me treguesit aktualë, vendi rrezikon të shkojë drejt “zhdukjes së pashmangshme”.
Propozimet e PD-së
Gjatë fjalës së tij, Berisha tha se opozita propozon një paketë të re mbështetëse për nxitjen e lindjeve, duke filluar nga buxheti i këtij viti. Sipas Berishës, ndihma financiare për familjet duhet të jetë si vijon:
Fëmija i parë: 1 mijë euro në vit
Fëmija i dytë: 2 mijë euro
Fëmija i tretë: 3 mijë euro
Fëmija i katërt dhe më shumë: 5 mijë euro bonus
Të gjitha këto të përllogaritura për 30 mijë lindje në vit, shkojnë 60 milionë euro “sepse ne kemi përllogaritur edhe kostot e kësaj ndërhyrje“, tha Berisha.
Ai shtoi se deri në vitin 2026, PD propozon që çdo fëmijë deri në moshën 6-vjeçare të marrë një bonus mujor prej 50 eurosh.
Bonusi mujor për fëmijët e lindur, ato ishin bonus i përnjëhershëm, bonusi mujor për fëmijët e lindur, me këtë buxhet, pra për vitin 2026, të jetë 50 euro për çdo fëmijë gjer në moshën 6 vjeç. 60 euro për çdo fëmijë, në moshën 6 deri 18-vjeçare. Vlera në vit për 30 mijë lindje i bie të jetë 15 milionë euro. Zero pagesë për fëmijën e tretë apo më shumë për çerdhe dhe kopshte.
“Të gjitha i paguan shteti.”, sipas tij.
Me këtë mbështeten të paktën 15 mijë fëmijë në vit dhe shuma e nevojshme nga buxheti për këtë masë është 5 milionë euro.
Propozime të tjera: “Rimbursim të ilaçeve për fëmijën e tretë apo më shumë në masën 120 euro në vit. Të paktën 8 mijë fëmijë përfitojnë nga kjo dhe shumë është 1 milion euro në vit rimbursim i plotë”.
Berisha theksoi se masat duhet të merren menjëherë për të frenuar largimin masiv të shqiptarëve dhe për të garantuar të ardhmen demografike të vendit. -
Dhuruesi i spermës i kaloi gjenin e kancerit 197 fëmijëve në vendet evropiane, përfshirë Shqipërinë
Spermë e një dhuruesi, mbartëse e një mutacioni të rrezikshëm të kancerit, ka sjellë në jetë të paktën 197 fëmijë në Europë, disa kanë vdekur
Një hetim i përbashkët i 14 organizatave mediatike, mes tyre edhe BBC, zbuloi se një dhurues sperme, i cili pa dijeninë e tij ishte mbartës i një mutacioni gjenetik shumë agresiv ka përdorur materialin e tij riprodhues për të sjellë në jetë të paktën 196–197 fëmijë në shumë vende të Europës. Disa prej këtyre fëmijëve kanë ndërruar jetë.
Sipas BBC-së, mutacioni prek gjenin TP53, i cili ndalon shndërrimin e qelizave në kancer. Edhe pse vetë dhuruesi nuk ishte i sëmurë, rreth 20% e spermës së tij mbante mutacionin që shkakton sindromën Li-Fraumeni, një gjendje që u jep fëmijëve deri në 90% gjasë të zhvillojnë kancer gjatë jetës, shpesh që në fëmijëri.“Kjo është një diagnozë e tmerrshme… një barrë e përjetshme për çdo familje,” deklaroi për BBC-në genetistja e kancerit në Londër, Clair Turnbull.
Spermë e përdorur për 17 vite
Dhuruesi ishte një student i paguar që nisi të jepte spermë në vitin 2005. Materiali i tij u përdor për gati 17 vjet nga klinika të ndryshme të fertilitetit. Ai kishte kaluar testet standarde, por mutacioni i tij ishte i paidentifikueshëm pa analiza shumë të avancuara.
Banka Evropiane e Spermës kërkoi ndjesë, duke thënë se mutacioni nuk mund të zbulohej paraprakisht dhe se dhuruesi u përjashtua menjëherë sapo doli në pah problemi.Fëmijë që u diagnostikuan me kancer, disa kanë vdekur
Rasti u zbulua kur mjekë nga vende të ndryshme raportuan fëmijë të sëmurë me kancer, të lidhur me të njëjtin dhurues. BBC raporton:“Hetimi zbuloi se numri total është të paktën 197 fëmijë… disa kanë zhvilluar dy lloje kanceri dhe disa kanë vdekur në moshë shumë të vogël.”
Genetisti Edwin Caspar nga Spitali Universitar i Rouen tha se situata është alarmante dhe raste të tjera mund të zbulohen në vitet në vijim.
Historia e ‘Céline’
BBC sjell edhe rrëfimin e “Céline”, një nëne franceze, vajza e së cilës, e lindur nga sperma e dhuruesit 14 vite më parë, rezultoi me mutacionin. Klinikë në Belgjikë e kontaktoi urgjentisht për testime.
Ajo shprehet pa mllef ndaj dhuruesit, por i revoltuar nga klinikat:“Më dhanë spermë që nuk ishte e sigurt. Nuk ishte e pastër.”
Sa i përket të ardhmes së vajzës së saj, ajo shton me frikë dhe vendosmëri:“Nuk e dimë kur, nuk e dimë kush dhe nuk e dimë sa. Por nëse ndodh, do të luftojmë. Dhe nëse ndodh shumë herë, do të luftojmë shumë herë.”
/vizionplus.tv -

Dhuruesi i spermës i kaloi gjenin e kancerit 197 fëmijëve në vendet evropiane, disa prej tyre nuk ia dolën
Spermë e një dhuruesi, mbartëse e një mutacioni të rrezikshëm të kancerit, ka sjellë në jetë të paktën 197 fëmijë në Europë, disa kanë vdekur
Një hetim i përbashkët i 14 organizatave mediatike, mes tyre edhe BBC, zbuloi se një dhurues sperme, i cili pa dijeninë e tij ishte mbartës i një mutacioni gjenetik shumë agresiv ka përdorur materialin e tij riprodhues për të sjellë në jetë të paktën 196–197 fëmijë në shumë vende të Europës. Disa prej këtyre fëmijëve kanë ndërruar jetë.
Sipas BBC-së, mutacioni prek gjenin TP53, i cili ndalon shndërrimin e qelizave në kancer. Edhe pse vetë dhuruesi nuk ishte i sëmurë, rreth 20% e spermës së tij mbante mutacionin që shkakton sindromën Li-Fraumeni, një gjendje që u jep fëmijëve deri në 90% gjasë të zhvillojnë kancer gjatë jetës, shpesh që në fëmijëri.“Kjo është një diagnozë e tmerrshme… një barrë e përjetshme për çdo familje,” deklaroi për BBC-në genetistja e kancerit në Londër, Clair Turnbull.
Spermë e përdorur për 17 vite
Dhuruesi ishte një student i paguar që nisi të jepte spermë në vitin 2005. Materiali i tij u përdor për gati 17 vjet nga klinika të ndryshme të fertilitetit. Ai kishte kaluar testet standarde, por mutacioni i tij ishte i paidentifikueshëm pa analiza shumë të avancuara.
Banka Evropiane e Spermës kërkoi ndjesë, duke thënë se mutacioni nuk mund të zbulohej paraprakisht dhe se dhuruesi u përjashtua menjëherë sapo doli në pah problemi.Fëmijë që u diagnostikuan me kancer, disa kanë vdekur
Rasti u zbulua kur mjekë nga vende të ndryshme raportuan fëmijë të sëmurë me kancer, të lidhur me të njëjtin dhurues. BBC raporton:“Hetimi zbuloi se numri total është të paktën 197 fëmijë… disa kanë zhvilluar dy lloje kanceri dhe disa kanë vdekur në moshë shumë të vogël.”
Genetisti Edwin Caspar nga Spitali Universitar i Rouen tha se situata është alarmante dhe raste të tjera mund të zbulohen në vitet në vijim.
Historia e ‘Céline’
BBC sjell edhe rrëfimin e “Céline”, një nëne franceze, vajza e së cilës, e lindur nga sperma e dhuruesit 14 vite më parë, rezultoi me mutacionin. Klinikë në Belgjikë e kontaktoi urgjentisht për testime.
Ajo shprehet pa mllef ndaj dhuruesit, por i revoltuar nga klinikat:“Më dhanë spermë që nuk ishte e sigurt. Nuk ishte e pastër.”
Sa i përket të ardhmes së vajzës së saj, ajo shton me frikë dhe vendosmëri:“Nuk e dimë kur, nuk e dimë kush dhe nuk e dimë sa. Por nëse ndodh, do të luftojmë. Dhe nëse ndodh shumë herë, do të luftojmë shumë herë.”
/vizionplus.tv -

Familjarët e 15-vjeçarit të vr*rë dalin në protestë: Shteti duhet të lëvizë
Me thirrjet ”thikat e Erionit mund të jenë thikat e një fëmijë tjetër nesër”, familjarët e 15-vjeçarit Erjon Boba që u vra me thikë nga një bashkëmoshatar më 25 nëntor në Durrës protestuan përpara Bashkisë. Ata kërkojnë drejtësi për djalin e tyre, teksa shprehen se lidhur me ngjarjen duhet të ketë një hetim të drejtë dhe të thelluar.
”Ne djali na iku e s’na kthehet më sikur bota të përmbyet, por prindërit që janë sot në çdo familje, apo mësuesit nëpër shkolla, mjekët, duhet të reflektojnë se nesër mund të ketë një Erion tjetër, një Martin tjetër. Kjo është plaga që le Erioni pas. Thikat e Erionit mund të jenë thikat e një fëmijë tjetër nesër. Edhe drejtësia për Erionin është shumë e vështirë, unë kam marrë me qindra mesazhe, dhe i falënderoj të gjithë shqiptarët për mesazhet e ngushëllimit, por ngushëllimi më i thellë do ishte të ishin sot këtu në këtë protestë të njoftuar.Në bëmë protestë dhe në Bulqizë, por ishte e dhimbshme mungesa e prindërve. E vërteta jonë është qe Erioni ka qenë i pafajshëm, një fëmijë i urtë i dashur, ishte edukuar me punën dhe me normat e familjes dhe jo të rrugës. Erioni është prerë në besë nga kjo shoqëri.
Nuk kemi asnjë lidhje dhe nuk na intereson kontakti me familjen e autorit. Na intereson vetëm drejtësia për Erionin. Po kanë ardhur nga shkolla e Erionit. Mendoj që fëmijët nuk janë lejuar sot të vijnë për shkak të orarit të shkollës. Kërkojmë të zbardhet çështja dhe autori të marri dënimin që meriton së bashku me shokët”,-është shprehur halla e Erjonit, Barie Cupi.
-

1 në 4 fëmijë nuk konsumojnë mëngjes, rritet rreziku i obezitetit
Një në katër fëmijë shqiptarë shkon në shkollë pa ngrënë mëngjes, duke anashkaluar vaktin më të rëndësishëm të ditës. Të dhënat e Institutit të Shëndetit Publik tregojnë se rreth 25% e nxënësve nuk konsumojnë mëngjes, një zakon që rrit rrezikun e mbipeshës dhe obezitetit.
Sipas raportit që mat sjelljet e shëndetshme të fëmijëve në moshë shkollore në të gjithë Europën, Shqipëria renditet ndër vendet e para për konsum të rregullt të frutave dhe perimeve nga të vegjlit. Megjithatë, mungesa e mëngjesit mbetet një problem shqetësues, pasi ndikon drejtpërdrejt në metabolizëm dhe kontrollin e peshës trupore.
Specialistët e shëndetit theksojnë se zakonet e shëndetshme ushqimore, kombinuar me aktivitet fizik të rregullt dhe kufizimin e kohës përpara ekraneve, janë faktorë kyç për parandalimin e mbipeshës. Obeziteti tek fëmijët po shndërrohet në një sfidë globale.
Të dhënat më të fundit tregojnë se 1 në 10 fëmijë të moshës 5–19 vjeç jeton me obezitet, duke u ekspozuar ndaj rreziqeve serioze shëndetësore si diabeti i tipit 2, sëmundjet kardiovaskulare dhe disa lloje kanceri.
Ekspertët apelojnë që prindërit të sigurojnë një mëngjes të balancuar çdo ditë, pasi ai ndihmon jo vetëm në mbajtjen e peshës së shëndetshme, por edhe në përqendrim, energji dhe performancë më të mirë në shkollë.
